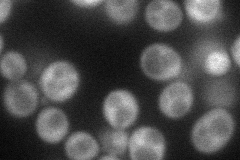
YDR283C
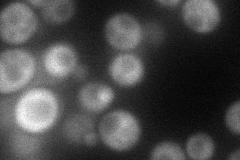
YDR283C
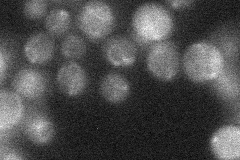
YDR283C
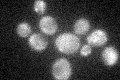
YDR283C
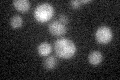
YDR283C

View description
Protein kinase, phosphorylates the alpha-subunit of translation initiation factor eIF2 (Sui2p) in response to starvation; activated by uncharged tRNAs and the Gcn1p-Gcn20p complex; contributes to DNA damage checkpoint control
Localization:
Intensity:
Fold change:
Significance:
-
C’ GFP library in SD

cytosol22.1 -
N' NOP1pr-GFP in SD
cytosol58.0209 -
N' TEF2pr-mCherry in SD
cytosol65.4396 -
N' NATIVEpr-GFP in SD
below threshold21.8843 -
N' TEF2pr-VC and Cyto-VN in SD

cytosol44.5616 -
C’ GFP library in SD+DTT

cytosol23.851.07No -
C’ GFP library in SD+H2O2
cytosol23.371.05No -
C’ GFP library in Starvation Media
cytosol21.450.97No -
C’ GFP library on the background of Pup2-DaMP

cytosol -
C’ GFP library on the background of CCT mutant

cytosol27.74951.25534No
